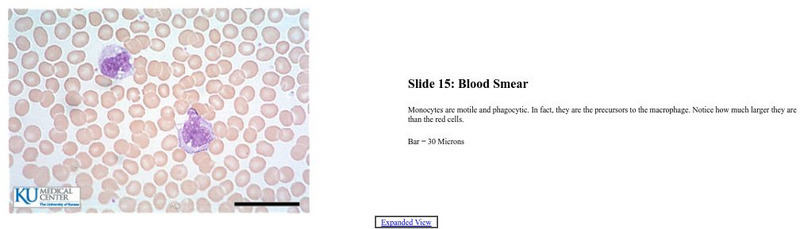

Hi, what do you want to do?
Curated OER
Blood
Although there are vocabulary terms in this PowerPoint that use British spelling, the presentation is attractive and educational. The content flows from the general composition of blood, into the different types of blood cells and their...
Curated OER
Human Blood: Microviewer
In this human blood: microviewer worksheet, students answer questions about blood, red blood cells, white blood cells, phagocytosis, blood type B, fibrin, sickle cells, and infected blood. Students also draw quick sketches of a human...
Give and Let Live
Blood and Transplant: Blood
Why is blood donation so important, anyway? Science and health classes across multiple grades benefit from an in-depth look into the need for and process of blood donation. With an emphasis on presenting the topic in a non-threatening...
Scholastic
Study Jams! The Immune System
A set of slides depicts sick children, an artistic rendition of a white blood cell amongst red blood cells, and a diagram of part of the lymph system to teach youngsters about immunity. Kids will find that it is made up of skin, white...
Curated OER
Microviewer
In this microviewer worksheet, students observe several types of cells. Students draw each type of cell and label the important parts. Students also answer questions relatable to the cell and the purpose for study.
Curated OER
The Battle of the Guts
Students listen to story, The Magic School Bus: Inside Ralphie, take notes from story on how body fights germs, identify different functions of immune system, and use Kid Pix slide show to explain how body fights viruses and bacteria.
Nuffield Foundation
A Closer Look at Blood
Here is a lab that has teenage scientists examining samples of their own blood under a microscope. Learners carefully prepare slides, then make detailed observations and identifying different types of cells using a key.
Curated OER
Cells
Students explore the types of cells and their appropriate function. After observing a PowerPoint presentation, students draw diagrams of cells. Using a specified website, students identify parts of plant and animal cells. They answer...
Curated OER
Translating Genetic Information
Young scholars explore the process of translation. They determine the correct sequencing and present their strands to the class. In addition, they compare normal red blood cells to sickle cells and complete discussion questions.
Curated OER
Biotechnology
A continuous cascade of information comes through this PowerPoint on biotechnology. The topic is defined, a history is presented, and basic genetic engineering techniques are explained. The topic is covered in an objective manner,...
Curated OER
Use of Microscopes and Creation of Slides
Students explore the use of microscopes and the creation of slides. They practice using, adjusting and viewing with a microscope. they view slides of familiar substances such as blood and fibers. In addition, they create slides using...
Curated OER
Circulatory System
The ciculatory system is introduced here by means of clear, labelled diagrams and charts with details. After learning the basics of the heart strucure, a sequence of slides help show the flow the blood as the heart muscle contracts. A...
Curated OER
Measuring Evolution of Populations
The Hardy-Weinberg principle is the focus of this concise slideshow. Some vocabulary definitions are given on the first 2 slides, and the rest are given over to examples of the Hardy-Weinberg theorem. Calculations of the H-W...
Curated OER
Proteins
As long as you have some support information to answer questions that may come up from students, this is an excellent PowerPoint to cover almost all aspects of protein structure and ionization. The sequence of slides has great...
Curated OER
What is the Immune System and How Does HIV Affect It?
Student discuss the effect of HIV on the immune system. For this human body lesson, students research the immune system and how the HIV virus weakens it. They create a bulletin board showing how HIV is transmitted.
Curated OER
My Favorite Biology Supplies
Here are some biology laboratory supplies that I can't live without.
Curated OER
Operating the spectrophotometer
Working in small groups, students explore the operation of spectrophotometer. Using the spectrophotometer, they investigate Beer's Law with everyday items.
Other
Your Doctor: Sickle Cell Anemia (In Arabic)
Photos of slides and genetics charts accompany the text and explain the differences between sickle cell train vs. sickle cell anemia, symptoms of sickle cell disease, secondary diseases/conditions associated with sickle cell, mechanism...
University of Kansas Medical Center
Univ. Of Kansas Medical Center: Blood Smear
This site, which is provided for by the University of Kansas Medical Center, gives a microscope slide of Red Blood cells (erythrocytes).